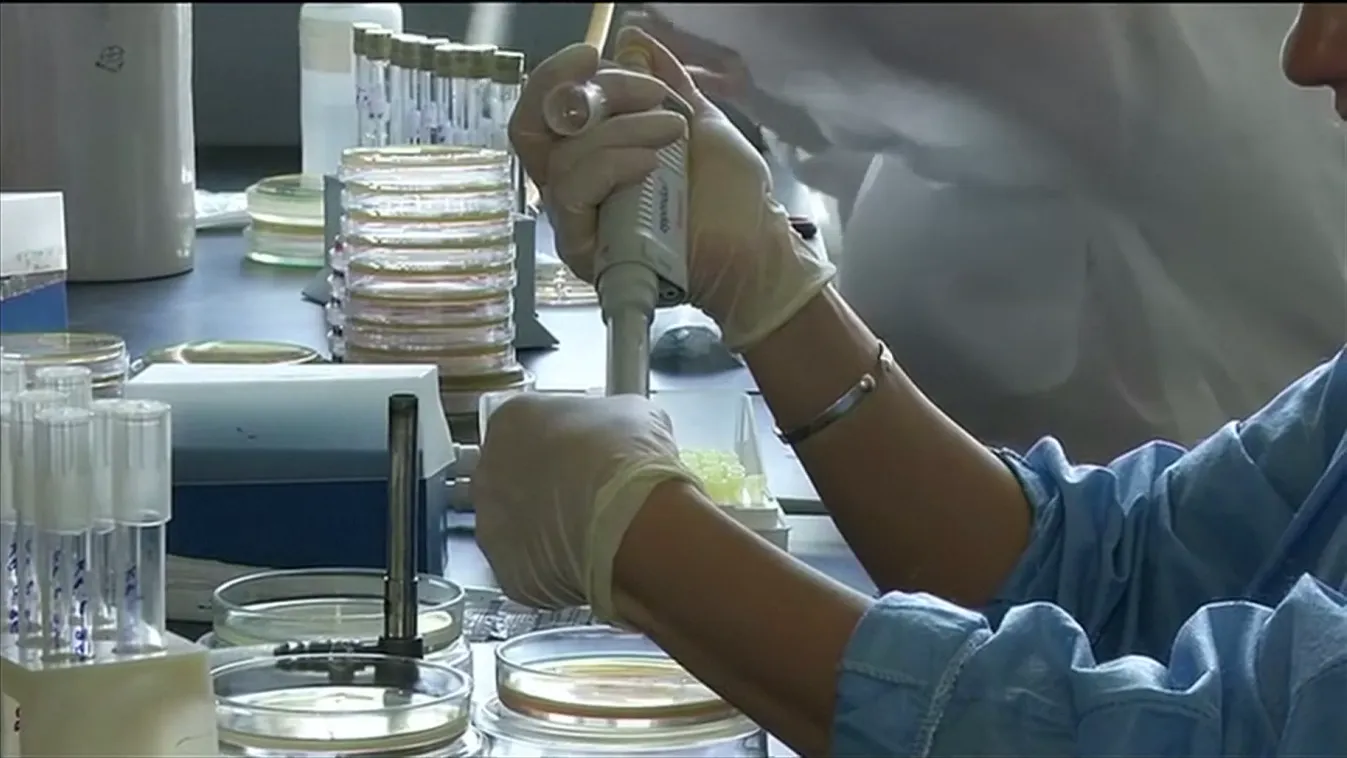
Nagy-Britanniában futótűzként terjed a kanyaró

Keresés
Cikk típusa
Rovatok
Műsor szerint
Dátum tartomány
járvány:
21-30 cikk megjelenítése a(z) 798-ből a keresett kifejezésre

Nagy-Britanniában futótűzként terjed a kanyaró

A téli szünet után megugorhat az influenzás megbetegedések száma + videó

Radar - Tombolnak a légúti megbetegedések + videó

Egyre nagyobb tempóban terjed a koronavírus új variánsa + videó

Karácsonykor tetőzik a covid Olaszországban + videó

Újra lehet vakcinára időpontot foglalni az EESZT-ben + videó

Visszatért a koronavírus-járvány, egyre több a beteg + videó

Szlávik János: Nagyon sok ember fog meghalni + videó











